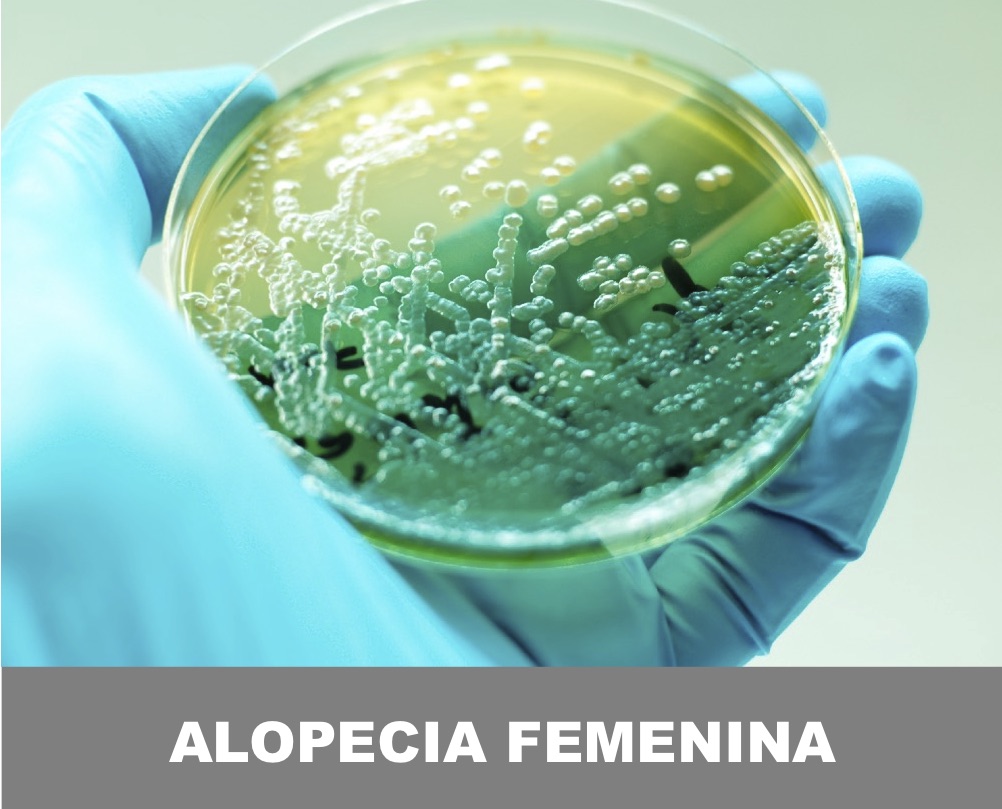
ALOPECIA FEMENINA VALENCIA

¿SABIAS QUE LA REGENERACIÓN CAPILAR PUEDE EVITAR QUE SIGAS PERDIENDO TU PELO?
A LA VANGUARDIA DE LA REGENERACIÓN CAPILAR
Nuestra unidad de regeneración capilar lleva más de 16 años investigando cómo identificar, revertir y tratar los diferentes tipos de alopecia que existen. Todos nuestros tratamientos son fruto de nuestras investigaciones I+D llevadas a cabo por un reputado grupo de dermatólogos especializados en el diagnóstico precoz y tratamiento de las patologías capilares.
Nuestro principal objetivo, con los más de 34.000 pacientes al año que tratamos, es conseguir la estabilización de la alopecia gracias a un diagnóstico temprano, así como la regeneración capilar revirtiendo la situación tomada como punto de partida.
El éxito de nuestros tratamientos radica en un diagnóstico especializado, un tratamiento individualizado según el tipo y grado de alopecia, y un seguimiento digital exhaustivo que asegure la regeneración y aumento de la densidad del cabello.